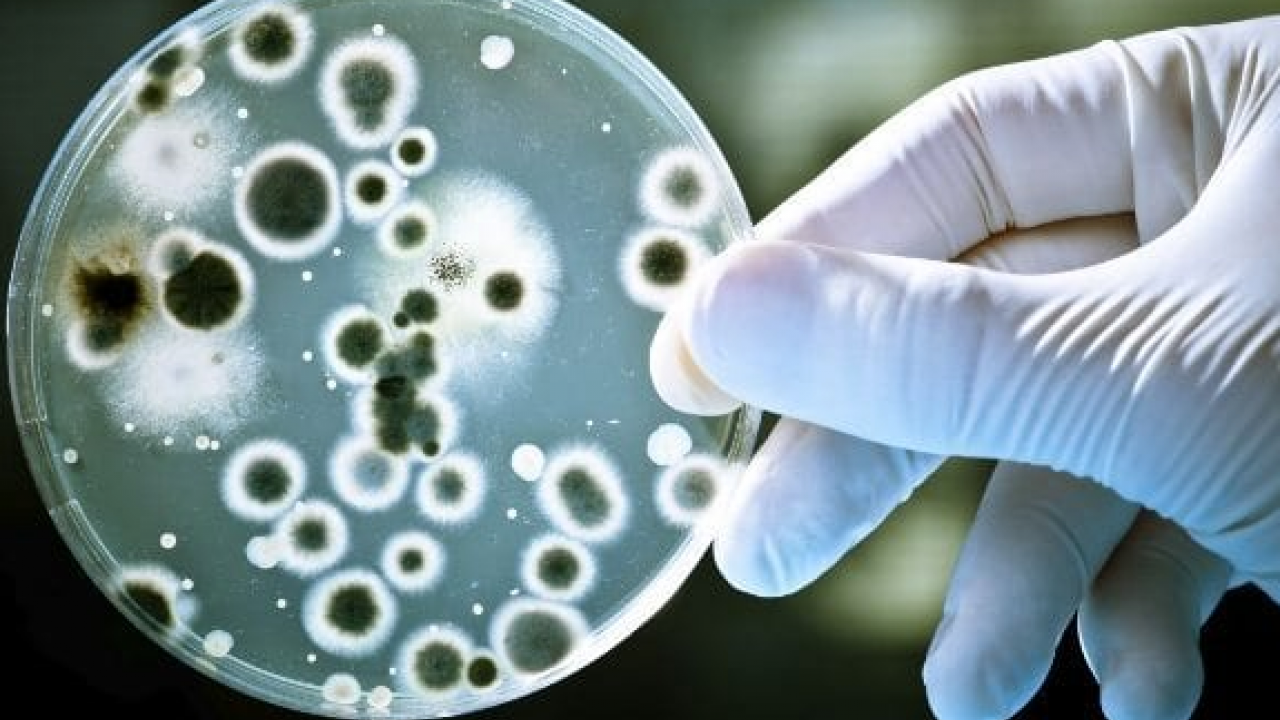
Foto - Prof. Dr. Murat Baş: Sağlıklı bir cilt için önce bağırsaklarınızı iyileştirin diyor!

Prof. Dr. Murat Baş: Sağlıklı bir cilt için önce bağırsaklarınızı iyileştirin diyor!
Prof. Dr. Murat Baş’a göre bağırsak sağlığı cilt hastalıklarıyla doğrudan ilişkili. Acıbadem Üniversitesi Sağlık Bilimleri Fakültesi Dekanı ve Beslenme ve Diyetetik Bölümü Başkanı Prof. Dr. Murat Baş, bağırsak sağlığının cilt hastalıklarıyla olan doğrudan ilişkisine dikkat çekiyor.